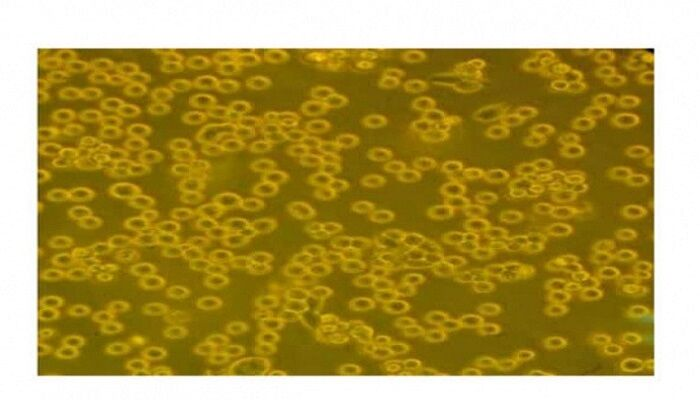

کاهش اثرات مخرب پرتودرمانی با استفاده از بوتئین
محققان مرکز تحقیقات بیوشیمی و بیوفیزیک دانشگاه تهران بر اساس پژوهشهای خود دریافتند بوتئین میتواند اثرگذاری دُز مفید پرتودهی را در سرطان معده افزایش دهد و در نتیجه، موجب کاهش اثر مخرب پرتودرمانی شود.
به گزارش گروه علم و آموزش ایرنا از دانشگاه تهران، به رغم کاهش کلی وقوع سرطان معده در جهان، این سرطان هنوز پنجمین سرطان رایج و سومین علت مرگومیر ناشی از سرطان در جهان است. همچنین بررسیها در ایران نشان داده بدون در نظر گرفتن سرطان پوست، سرطان معده جزو پنج سرطان اول در بین مردان (اولین) و زنان (سومین) است.
پرتودرمانی یکی از روشهای درمان سرطان است که تقریباً برای ۵۰ درصد از بیماران سرطانی استفاده میشود. در دهههای اخیر، استفاده از ترکیباتی که بتوانند اثر پرتو یونیزان را بر بافتهای سرطانی افزایش دهند، همواره موضوع تحقیق و بررسی بوده است.
بوتئین متعلق به خانواده فلاونوئیدها است. این ترکیب در تعداد زیادی از گیاهان که برای درمان سرطان استفاده میشوند، وجود دارد. عملکرد آنتیاکسیدانی، ضدسرطانی، ضددیابتی و ضدالتهابی از جمله ویژگیهای این ترکیب است.
در مطالعه تازه محققان مرکز تحقیقات بیوشیمی و بیوفیزیک دانشگاه تهران، استفاده از بوتئین به همراه پرتودهی در رده سلولی سرطان معده، باعث افزایش میزان آسیبهای ایجادشده در ماده وراثتی، افزایش میزان مرگومیر این سلولها و نیز باعث اختلال در چرخه سلولی شده است. از این رو، این ترکیب میتواند به عنوان یک حساسکننده پرتویی مطرح شود و بررسیهای بیشتری در این زمینه انجام گیرد.
محققان مرکز تحقیقات بیوشیمی و بیوفیزیک دانشگاه تهران اعلام کردند بوتئین میتواند اثرگذاریِ دُز مفید پرتودهی را در سرطان معده افزایش و در نتیجه، اثر مخرب پرتودرمانی را کاهش دهد.
این نتایج بر اساس یافتههای رساله دکتری زهرا حبیبی کلیشمی با عنوان «مطالعه تأثیر تیمار ترکیبی بوتئین و پرتو ایکس روی رده سلولی سرطان معده، MKN_۴۵» با راهنمایی دکتر بهرام گلیایی استاد مرکز تحقیقات بیوشیمی و بیوفیزیک دانشگاه تهران حاصل شده است.